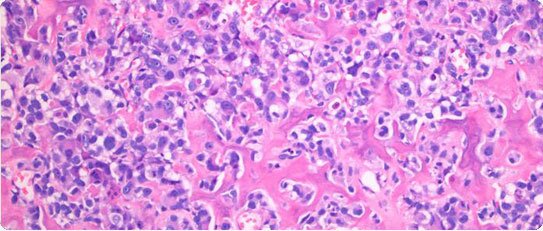

The service has a large team of musculoskeletal radiologists providing highly specialist expertise in CT, MRI, ultrasound and nuclear medicine in the evaluation of bone and soft tissue tumours.
Specialist diagnostic histopathology is provided by a team of dedicated bone and soft tissue tumour pathologists, and also includes molecular genetics to identify characteristic chromosomal translocations and gene mutations (abnormalities of the genetic material at the centre of the tumour cell), now an essential component of a state-of-the-art diagnostic service.